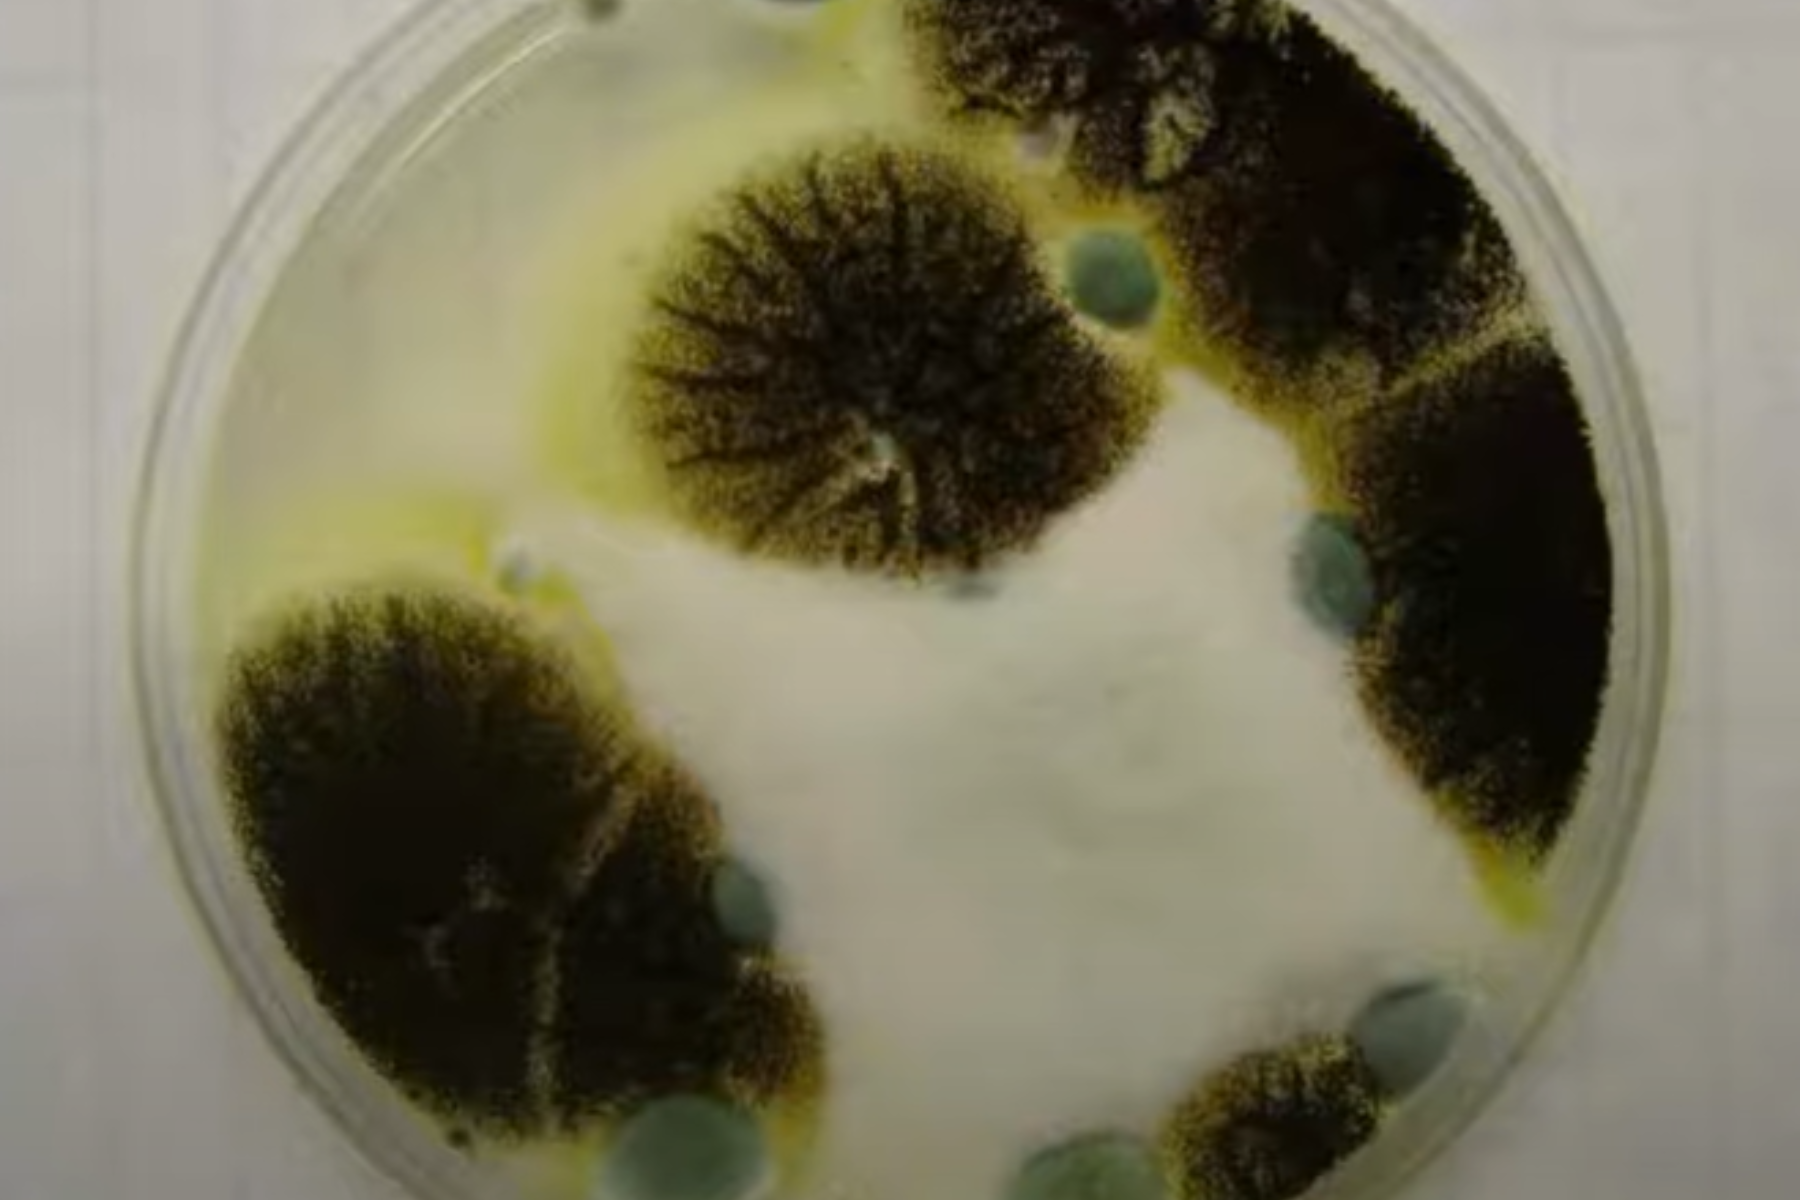

13 вересня: яке сьогодні свято, традиції та заборони

13 вересня в Україні відзначають День українського кіно та День фізичної культури і спорту. За церковним календарем віряни вшановують пам'ять святого священномученика Корнилія. У світі святкують День обізнаності про вроджені вади розвитку домашніх тварин.
«Главком» розповідає про свята, історію, традиції та прикмети 13 вересня 2025 року.
Зміст
- Свята в Україні
- Міжнародні та національні свята
- Релігійні свята та їхня історія
- Народні вірування та прикмети
- Історичні події
- Іменини
Свята в Україні
День українського кіно

Щорічно у другу суботу вересня в Україні відзначається День українського кіно. Свято було започатковано указом Президента України від 12 січня 1996 року і призначено на другу суботу вересня.
Історія українського кінематографу починається з 1893 року. Йосип Тимченко, механік Одеського університету, зібрав перший у світі апарат, що вмів знімати та відтворювати кіно (знаменитий винахід братів Люм’єр з’явився на два роки пізніше). Тоді кінематограф називали «рухомою фотографією». Перший в Україні сеанс кіно відбувся 2 грудня 1896 року в Харківському оперному театрі, сучасній обласній філармонії. На сеансі було показано декілька короткометражних стрічок, відзнятих у Харкові українським фотографом та першим оператором хроніко-документальних фільмів Альфредом Федецьким. Відтоді по Україні у містах Дніпро (тодішньому Катеринославі), Київ та Одеса почали з’являтися невеликі кіностудії, які знімали перші водевілі, комедії та драми.
День фізичної культури і спорту в Україні

Це свято відзначається у другу суботу вересня і присвячене спортсменам, тренерам та всім, хто популяризує здоровий спосіб життя. Свято підкреслює важливу роль фізичної активності у житті суспільства.
День українського борщу

День українського борщу – поки неофіційне свято, воно було запропоноване для відзначення щороку у другу суботу вересня. У січні 2022 року Комітетом Верховної Ради України з гуманітарної та інформаційної політики було подано проект постанови №6361 про встановлення Дня українського борщу.
Проєкт так і не розглянули, що не дивно під час війни. Але соцмережі та любов до традиційної страви – зробили свою справу. Подія вже популярна і можна сказати всенародна.
Перша згадка про борщ в історичних документах датується кінцем жовтня 1584 року. Однак, зважаючи на інші знаменні дати, що відзначаються в Україні протягом жовтня, було вирішено перенести День борщу на другу суботу вересня. Цей період є ідеальним, оскільки всі інгредієнти для українського борщу доступні, а погода все ще досить тепла для туристичних активностей на свіжому повітрі.
Міжнародні та національні свята
День обізнаності про вроджені вади розвитку домашніх тварин

Цей день присвячений підвищенню обізнаності про вроджені аномалії, які можуть вражати наших домашніх улюбленців. Ініціатором цього дня став Девіс Роджерс, засновник фонду MBJungle Foundation.
Мета свята – інформувати власників тварин про важливість профілактики, лікування та догляду за тваринами з вродженими вадами. Вроджені дефекти можуть бути різного ступеня тяжкості: від незначних до таких, що загрожують життю.
День народження пеніциліну
13 вересня відзначають День народження пеніциліну – це випадкове відкриття, що зробило революцію в медицині
13 вересня 1928 року світ став свідком доленосної події в історії медицини – випадкового відкриття пеніциліну Олександром Флемінгом. Цю дату часто відзначають як «день народження» пеніциліну, що знаменує початок революційної епохи в медицині.
Олександр Флемінг, шотландський бактеріолог, проводив дослідження в лікарні Святої Марії в Лондоні, коли натрапив на цю революційну знахідку. Він вивчав бактерії стафілокока і залишив чашку Петрі з бактеріями на своєму лабораторному столі без кришки, коли поїхав у відпустку. Повернувшись, він помітив дещо дивовижне: на чашці розвинулася пліснява під назвою Penicillium notatum, яка ефективно пригнічувала ріст бактерій, що її оточували.
Релігійні свята та їхня історія
День пам’яті святого священномученика Корнилія

13 вересня православна церква вшановує пам’ять святого священномученика Корнилія. Він був римським сотником, який жив у І столітті в Кесарії Палестинській. Святий Корнилій був благочестивим і богобоязливим язичником, який допомагав бідним. Згідно з переказами з Діянь апостолів, до нього з'явився Ангел, який наказав знайти апостола Петра. Після зустрічі з Петром Корнилій і вся його родина першими серед язичників прийняли християнство і були хрещені. Згодом Корнилій став єпископом і навертав людей до віри, за що прийняв мученицьку смерть.
Народні вірування та прикмети
За народними прикметами, цього дня звертають увагу на такі знаки:
- Якщо вітер дме із заходу, зима буде дощовою.
- Якщо на дубах рано опало листя, зима буде холодною.
- Туман вранці обіцяє теплу та сонячну погоду.
Історичні події
- 1776 рік – засноване місто Дніпро;
- 1788 рік – Нью-Йорк проголошений столицею США;
- 1848 рік – у Львівському університеті створена кафедра української мови;
- 1902 рік – у Великій Британії вперше як доказ провини обвинуваченого були використані відбитки його пальців з місця злочину;
- 1960 рік – президент США Двайт Ейзенгавер підписав указ про встановлення пам'ятника Тарасові Шевченку у Вашингтоні;
- 1989 рік – в Україні виявлено перших хворих на СНІД: ними виявилися дві молоді мешканки Києва;
- 1993 рік – підписана угода між Ясіром Арафатом і Іцхаком Рабином про визнання Палестинської автономії.
Іменини
Цього дня День ангела святкують: Олексій, Володимир, Іван, Михайло.
Останні новини
